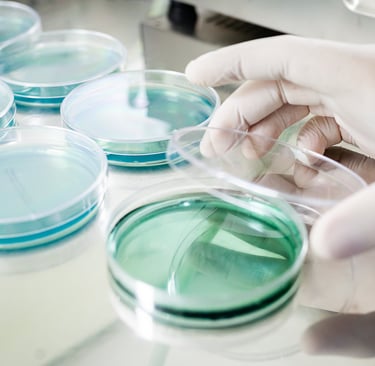

Nossos Produtos
Produzimos preparações químicas feitas em laboratórios que fornecem nutrientes para o crescimento e desenvolvimento de microrganismos fora do seu habitat natural como por exemplo fungos e as bactérias, chamados de Meios de Cultura.




Ágar MacConkey
Amplamente utilizado no setor de microbiologia, esse meio é empregado para diversas amostras e é destinado ao crescimento de bactérias Gram negativas, ou seja, inibe bactérias Gram positivas. As bactérias que fermentam lactose tornam o meio rosa choque e as bactérias que não são fermentadoras de lactose tornam o meio amarelo claro.
Ágar Cistina Lactose Eletrólito Deficiente (CLED)
Meio de cultura muito utilizado na rotina para cultura de urina, tem coloração verde clara onde apresenta coloração amarelada para colônias de microrganismo fermentador de lactose e coloração azul para não fermentadores de lactose.




Meio de cultura frequentemente usado para testes de sensibilidade a antimicrobianos e para testes complementares.
Meio de cultura que promove a identificação presuntiva dos principais patógenos que causam a infecção do trato urinário através da detecção, por agentes cromogênicos específicos, da atividade enzimática bacteriana sobre determinados substratos.
Agar Cromogênico I.T.U.
Ágar Mueller Hinton




Ágar Salmonella-Shigella (SS)
Ágar Cromogênico Candida
Meio de cultura utilizado para o isolamento de Salmonella sp.e Shigella sp. a partir de amostras clínicas fecais. Ele também pode ser usado como um segundo meio de isolamento, como parte dos métodos padrão pesquisa para Salmonella spp..
Meio de cultura que promove a identificação presuntiva dos principais patógenos fúngicos que causam a infecção do trato urinário através da detecção, por agentes cromogênicos específicos, da atividade enzimática sobre determinados substratos.
Ágar Sabouraud
Ágar Mycosel
Ágar Chocolate
Ágar Sangue
"Frase de Impacto sobre um diferencial dos nossos produtos"
Bruno ou Carliane


★★★★★